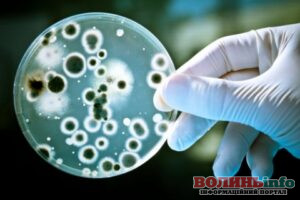
news

Волинянин помер від лістеріозу: що за хвороба та як від неї вберегтися?
На початку року в Рожищенській громаді і зареєстровано випадок лістеріозу в 62-річного чоловіка, він помер.
Триває комплекс протиепідемічних заходів в осередку захворювання. Фахівці центру вивчають умови проживання, харчування та побуту.
Читайте також: “Кидали” таксистів на гроші: на Волині в одній з колоній викрили шахрайську схему
Встановлено, що у господарстві утримуються свійські тварини (корова, свині, собаки, кіт), з якими контактував чоловік. У вогнищі відібрано матеріал для проведення лабораторних досліджень. Здійснено комунікаційні заходи щодо профілактики хвороби.
Лістеріоз – інфекційне захворювання, спричинене бактеріями, котрі широко розповсюджені у природі, у ґрунті, піску та воді.
Група ризику лістеріозу
Діти першого року життя та вагітні – серед найбільш вразливих щодо лістеріозу.
До групи ризику також належать люди зі зниженим імунітетом. Це ті, хто отримує хіміо- і гормональну терапію, має СНІД та цукровий діабет, люди похилого віку.
Загалом сприйнятливість до лістерій у людей невисока. Наша імунна система вміє боротися з цими бактеріями, не допускаючи розвитку хвороби.
Розповсюдження лістеріозу
Джерелом лістерій є гризуни, сільськогосподарські тварини (особливо вівці, корови й свині), домашні і дикі тварини (бродячі коти і собаки), а також дикі птахи, зокрема, голуби. Тварини виділяють лістерії в зовнішнє середовище з випорожненнями, сечею, носовим слизом, молоком, навколоплідною рідиною.
Зараження людини в основному відбувається при контакті з інфікованими тваринами та птахами чи їх продуктами життєдіяльності (наприклад, під час догляду); при вживанні рибної або тваринної продукції без термічної обробки (сире молоко, сирокопчені ковбаси, сир, особливо, придбаний на стихійних ринках); через забруднені овочі та фрукти.
Симптоматика хвороби
Хвороба характеризується ураженням центральної нервової системи, септичними проявами, абортами, маститами або перебігає у формі безсимптомного носійства. За першими симптомами вона схожа на харчове отруєння. У випадку прогресування хвороби страждає центральна нервова система (головний мозок). Тому важливо звернутись до лікаря, якщо з’явилися ознаки харчового отруєння: слабкість, озноб, підвищена температура, діарея, блювота. Іншою формою хвороби може бути ангінозно-септична, яка нагадує ангіну. У разі ураження нервової системи з’являються ознаки менінгіту, менінгоенцефаліту або абсцесу мозку.
Профілактика лістеріозу
Профілактика залишається найкращим методом боротьби з лістеріозом. Для профілактики лістеріозу важливо робити належну термічну обробку харчових продуктів (варіння, смаження, запікання), котра на 100% знищує лістерії. Перед вживанням сирих овочів і фруктів потрібно ретельно їх мити, адже лістерії можуть бути на поверхні. Не варто вживати пошкоджені плоди (падалицю, з тріщинами, розломами) — якщо лістерії були на їх поверхні або в ґрунті, вони могли проникнути всередину. Важливо, що розігрівання у мікрохвильовій печі, бланшування, розморожування при кімнатній температурі не вбиває мікроорганізми.
Варто мити овочі і фрукти відразу, принісши їх додому. Особливістю лістерій є їх здатність розмножуватися в харчових продуктах навіть в умовах холодильника і морозильної камери.
При приготуванні їжі не розміщуйте сирі і готові продукти поруч. Не можна різати варені овочі для салату на дошці, де ви тільки що розрізали сире м’ясо. Сирі та готові продукти не можна зберігати на одній полиці в холодильнику.
Дотримуйтеся заходів особистої гігієни, мийте руки після відвідування вулиці, туалету та громадських місць. Мийте руки перед вживання їжі. Використовуйте воду з перевіреною якістю.
Не купуйте продукти на стихійних ринках, де ви не можете бути впевнені в їх якості та належних умовах зберігання, транспортування, приготування.
Читайте також: Новий випадок кору на Волині: захворювання діагностовано у 4-річної дитини
За інформацією: Волинського обласного центру з контролю та профілактики хвороб
Фото ілюстративне з інтернету
Автор статті: Малашкевич Анна




